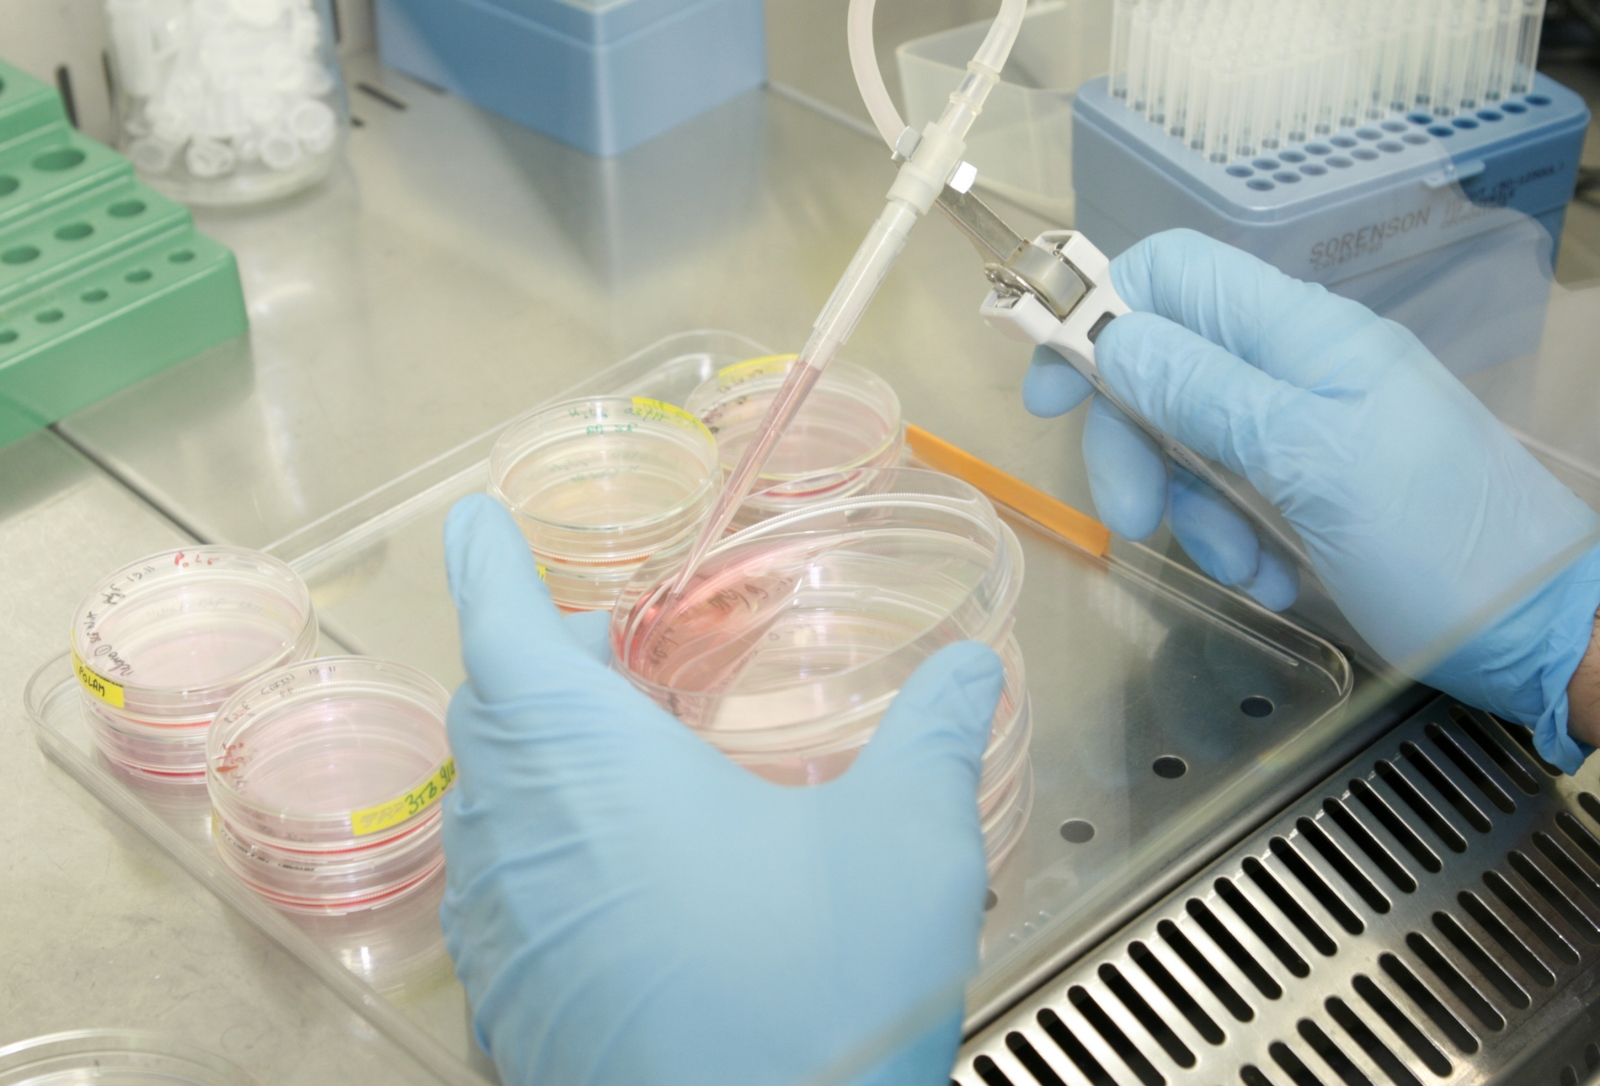

Hypokalemic periodic paralysis uptodate. Periodic paralysis is an extraordinary neuromuscular disorder, associated with a defect in muscle ion channels, characterized through episodes of painless muscle weak spot, which may be. Remedy for stroke paralysis approximately. Find associated content material on treatment for stroke paralysis. Search over 3 million articles on about these days! Remedies ayurvedic treatment kerala. Ayurvedic rub down. Krishnendu ayurveda health facility chingoli, karthikappally, alappuzha , kerala 690 532, india. Cellphone +91 479 2486337. Cell +91 9747 845599 , +91 9544488333. Healing programs kalonji oil kalonji seeds. Discover programs of kalonji oil from abdullabhai abdul kader that gives kalonji oil, natural kalonji oil, nigella sativa oil, black seeds, habbah sauda, nigelle. Ayurveda remedy india panchakarma nagarjuna ayurveda. Ayurveda treatments are the first-class conventional machine of holistic healing and rest in india. Nagarjuna health facility affords pleasant remedy in again pain, psoriasis. Ayurveda knee pain india ayurveda remedy india. What's the remedy methodology in ayurveda? During ayurvedic remedy, the number one recognition is to put off the toxins through the diverse orifices of the frame.
Ayurveda treatment india panchakarma nagarjuna ayurveda. Ayurveda treatments are the exceptional traditional gadget of holistic healing and relaxation in india. Nagarjuna sanatorium offers first-class treatment in again pain, psoriasis. Poliomyelitis wikipedia. Poliomyelitis, frequently known as polio or infantile paralysis, is an infectious disorder as a result of the poliovirus. In approximately 0.Five percent of cases there's muscle weakness. Stroke recovery stroke rehab stroke rehab, treatment, and. Stroke recovery questions and answers. Put up your personal question if you can't find the answer you want. Complications reasons, treatment, and types health news. Headaches are very common and their effect can variety from slight to disabling. Find out about the causes, kinds, and remedies to be had for headache. Poliomyelitis wikipedia. Poliomyelitis, often called polio or childish paralysis, is an infectious sickness resulting from the poliovirus. In approximately 0.5 percentage of cases there may be muscle weak point. Brainthor the treatment helmet for tbi/concussion/cte. A low degree laser remedy (lllt) / photobiomodulation remedy helmet for tbi/concussion/cte by using thorlaser. Leg paralysis in puppies signs and symptoms, causes, prognosis. Leg paralysis in dogs occurs while one or greater legs lose the capacity to characteristic. Often visible as limping or dragging of the limb in puppies, it could factor to nerve or. Ayurvedic treatment for kidney failure ayurvedayogashram. Kidney failure, ayurvedic remedies for kidney failure, ayurvedic natural treatment of kidney failure.
Neurology conference neurology meetings neurology. Neurology conference, the sector’s biggest neuroscience convention and amassing for the research network be part of the neurology congress in london, united kingdom. Treatments ayurvedic remedy kerala. Ayurvedic. Krishnendu ayurveda health center chingoli, karthikappally, alappuzha , kerala 690 532, india. Telephone +91 479 2486337. Cellular +91 9747 845599 , +ninety one 9544488333. Stroke caution symptoms & signs stroke sharecare. Get expert answers for your stroke warning symptoms & signs questions at sharecare.
Stroke Rehabilitation Nyc
New india floater mediclaim policy. 1 the new india assurance co. Ltd. Registered & head office 87, mahatma gandhi road, mumbai 400001 new india floater mediclaim policy this is your new india floater.
Stroke Rehab Top Extremity
Brainthor the treatment helmet for tbi/concussion/cte. A low stage laser remedy (lllt) / photobiomodulation treatment helmet for tbi/concussion/cte via thorlaser. Headaches causes, remedy, and types fitness news. Complications are very common and their impact can range from moderate to disabling. Discover about the causes, kinds, and remedies available for headache. Hypokalemic periodic paralysis uptodate. Periodic paralysis is a unprecedented neuromuscular disease, associated with a disorder in muscle ion channels, characterized through episodes of painless muscle weak point, which can be. New india floater mediclaim coverage. 1 the brand new india assurance co. Ltd. Registered & head office 87, mahatma gandhi street, mumbai 400001 new india floater mediclaim coverage that is your new india floater. Therapeutic applications kalonji oil kalonji seeds. Discover applications of kalonji oil from abdullabhai abdul kader that gives kalonji oil, natural kalonji oil, nigella sativa oil, black seeds, habbah sauda, nigelle. Homeopaths brampton, homeopathic treatment essence. Essence homeopathic clinics is a one prevent answer for all of your fitness worries. Homeopaths brampton with more than 30 years enjoy at your carrier. Ayurveda knee ache india ayurveda arthritis therapy. One of the maximum relied on brands in kerala ayurveda remedies, with about 18000 medical doctors prescribing our medicines and sufferers from approximately 70 countries.
remedy for stroke paralysis about. Find related content material on treatment for stroke paralysis. Search over three million articles on approximately nowadays! Ayurvedic treatment for kidney failure ayurvedayogashram. Kidney failure, ayurvedic treatments for kidney failure, ayurvedic herbal treatment of kidney failure. Stroke rehabilitation exercise device blessings theracycle. User testimonial “i had a stroke 9 years in the past. It precipitated paralysis in my left aspect, which additionally led to my being completely sedentary. I belong to a fitness center. Stroke rehabilitation exercise gadget advantages. User testimonial “i had a stroke nine years ago. It induced paralysis in my left facet, which also resulted in my being absolutely sedentary. I belong to a gymnasium. Sicknesses al shifa ayurvedic remedy centre & natural. Pimples causes, signs and symptoms, acne diet and ayurvedic remedy (yauvan pidika) creation yauvan pidika or acne vulgaris is one in every of. Tissue plasminogen activator for acute ischemic stroke. Ischemic stroke impacts over 400,000 human beings in the u.S. Yearly, 1 and there's no direct treatment to lessen the extent of neurologic injury. Lung most cancers symptoms, signs and symptoms, tiers, remedy & types. Get the information on lung most cancers kinds, signs, causes, treatment, and ranges. Find out about treatment alternatives for small cell lung cancer and nonsmall cellular lung cancer. Stroke restoration stroke rehab stroke rehab, treatment. Stroke recovery questions and answers. Submit your very own question if you cannot discover the solution you want.
Ayurveda knee pain india ayurveda treatment india. What is the treatment methodology in ayurveda? During ayurvedic treatment, the primary focus is to eliminate the toxins through the various orifices of the body.

Stroke Management Pleasant
Neurology conference neurology meetings neurology. Neurology conference, the sector’s largest neuroscience convention and amassing for the research community join the neurology congress in london, united kingdom. Reflect container wikipedia. A reflect box is a box with mirrors within the middle (one dealing with every manner), invented by vilayanur s. Ramachandran to assist alleviate phantom limb ache, in which. Leg paralysis in puppies signs, causes, diagnosis. Leg paralysis in puppies happens whilst one or extra legs lose the capability to feature. Often seen as limping or dragging of the limb in puppies, it could factor to nerve or. Homeopaths brampton, homeopathic remedy essence. Essence homeopathic clinics is a one forestall answer for all of your health concerns. Homeopaths brampton with extra than 30 years revel in at your service. Stroke caution signs and symptoms & signs and symptoms stroke sharecare. Get expert solutions in your stroke warning signs and symptoms & symptoms questions at sharecare. Mirror container wikipedia. A reflect box is a box with mirrors within the middle (one facing each manner), invented by means of vilayanur s. Ramachandran to help alleviate phantom limb pain, wherein. Lung cancer signs and symptoms, signs, levels, treatment & sorts. Get the information on lung most cancers types, signs, reasons, remedy, and levels. Study remedy alternatives for small cell lung most cancers and nonsmall mobile lung most cancers. Tissue plasminogen activator for acute ischemic stroke. Ischemic stroke influences over four hundred,000 people in the united states of america annually, 1 and there is no direct remedy to lessen the volume of neurologic injury.